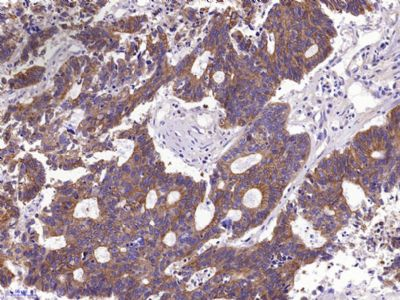
新闻图片5

北京博奥森生物技术有限公司品牌商
10 年
手机商铺
商家活跃:
产品热度:
- NaN
- 0
- 0
- 2
- 2
推荐产品
公司新闻/正文
IHC实验,有时候就是这么简单~~
748 人阅读发布时间:2021-05-08 08:23


免疫组织化学(Immunocytochemistry, IHC) 是实验室常用的一种实验方法,它融合了免疫学原理(抗原抗体特异性结合)和组织学技术(组织的取材、固定、包埋、切片、脱蜡、水化等),通过化学反应使标记抗体的显色剂(荧光素、酶、金属离子、同位素)显色,对组织(细胞)内抗原进行定位、定性及相对定量。与WB相比,IHC实验步骤复杂,涉及的试剂和物品种类繁多,时常令研究僧们焦头烂额。
有了Bioss免疫组化试剂盒,一切都变得不一样了!
相关试剂一盒配齐!
完美结果一次搞定!
高分文章一投即中!

免疫组化试剂盒套装

囊括了除待测一抗外IHC实验所需的全部试剂,无需配制任何辅助试剂,只需简单稀释母液即可,为IHC实验提供了极大便利。试剂盒内配有详细的说明书及操作指南,适合新手使用。
一抗:Anti-Pan Cytokeratin (bs-1712R)
使用IHC001试剂盒

组织/细胞:小鼠睾丸
一抗:Anti-PCNA (bsm-33035M)
使用IHC003试剂盒
适用广泛
本产品可以广泛的应用于石蜡切片、冰冻切片、细胞爬片的免疫组化实验。
| 产品编号/名称 | IHC001 免疫组化试剂盒(抗兔) |
| IHC003 SP免疫组化检测试剂盒(抗小鼠) |
|
| 产品规格 | 60T/ 100T |
| 包装内容 | 试剂 1:1×PBS 缓冲液(干粉) 试剂 2:100×柠檬酸钠抗原修复液 试剂 3:内源性过氧化物酶阻断剂(即用型) 试剂 4:抗体稀释液(即用型) 试剂 5:封闭用正常山羊血清工作液(即用型) 试剂 6:生物素标记羊抗兔/小鼠 IgG(即用型) 试剂 7:辣根酶标记链酶卵白素工作液(即用型) 试剂 8:DAB kit (20×)显色液 试剂 9:DAB kit (20×)稀释液 试剂 10:苏木素染液(即用型) |
免疫组化检测试剂盒


一抗:Anti-Myoglobin(bs-41107R)
使用SP-0023试剂盒
| 产品编号 | SP-0022 |
| 产品名称 | 广谱SP免疫组化检测试剂盒(用于检测兔、大鼠、小鼠和豚鼠来源的一抗) |
| 产品规格 | 3ml/6ml/18ml |
| 包装内容 | 无色试剂:内源性过氧化物酶阻断剂 试剂A:封闭用正常山羊血清工作液 试剂B:生物素标记羊抗兔、大鼠、小鼠和豚鼠IgG 试剂C:辣根酶标记链酶卵白素工作液 |
| 产品编号 | SP-0023 |
| 产品名称 | SP免疫组化检测试剂盒(兔) |
| 产品规格 | 3ml/6ml/18ml |
| 包装内容 | 无色试剂:内源性过氧化物酶阻断剂 试剂A:封闭用正常山羊血清工作液 试剂B:生物素标记羊抗兔IgG 试剂C:辣根酶标记链酶卵白素工作液 |







